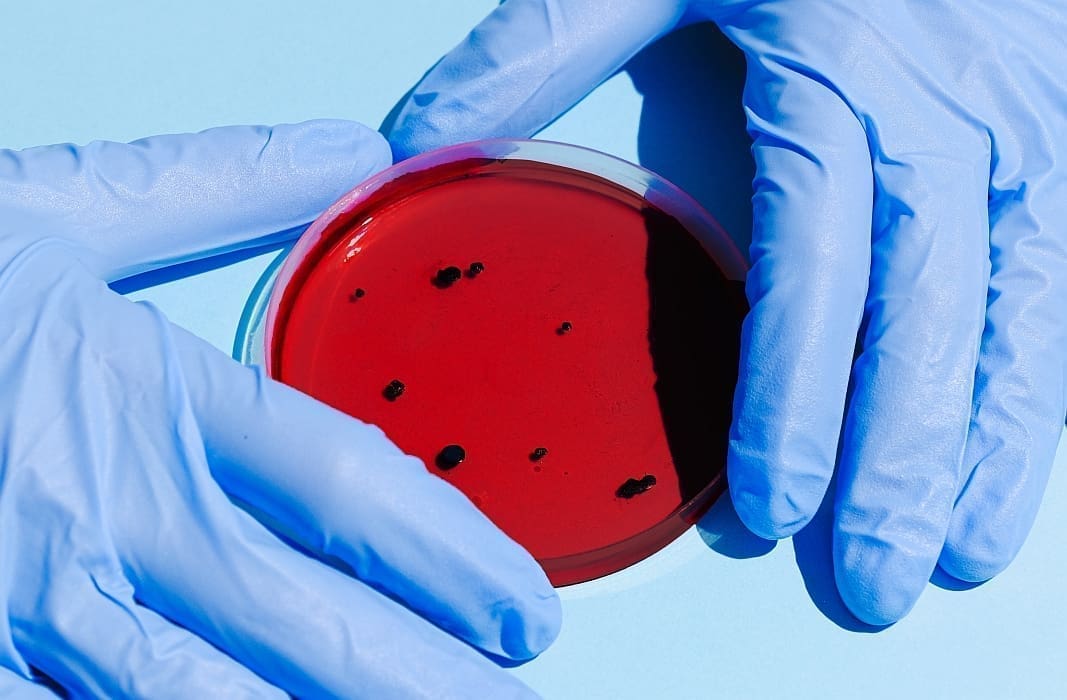

Virus Zapadnog Nila potvrđen je kod još sedam osoba u Srbiji pa se ukupan broj zaraženih u ovoj sezoni popeo na 34, izvijestio je u petak Institut za javno zdravstvo Srbije "Dr. Milan Jovanović Batut".
Prosječna starost oboljelih je 65 godina, a više je zaraženo muškaraca nego žena.
Zaraženi su potvrđeni u 12 okruga u Srbiji, s novim slučajem zabilježenim u Sjevernobanatskom okrugu.
Deset slučajeva zaraze zabilježeno je u Beogradu, osam slučaja u Južnobačkom okrugu, po tri u Srednjobanatskom i Južnobanatskom, po dva u Moravičkom i Sjevernobanatskom te po jedan slučaj u Pomoravskom, Podunavskom, Raškom, Braničevskom, Šimadijskom i Zapadnobačkom okrugu.
Prvi slučaj otkriven je 12. srpnja kod muškarca od 66 godina, prenosi Blic.
U Europskoj uniji do sad su potvrđeni slučajevi zaraze Zapadnog Nila u Grčkoj, Italiji, Rumunjskoj, Francuskoj, Bugarskoj, Mađarskoj, Španjolskoj i Albaniji.
Europa je ove godine potvrdila rekordan broj oboljelih od bolesti koje prenose komarci, kao što su čikungunja groznica i virus Zapadnog Nila, objavila je europska agencija za zdravlje. ECDC je savjetovao stanovnicima pogođenih regija da se zaštite od uboda komaraca repelentima, nošenjem dugih rukava i hlača te mrežama protiv komaraca.
Bolest Zapadnog Nila prenose komarci, a rezervoar su divlje ptice, prvenstveno selice. Na ljude, kopitare i druge sisavce virus se prenosi ubodom zaraženog komarca.
Bolest se ne prenosi s čovjeka na čovjeka kontaktom.